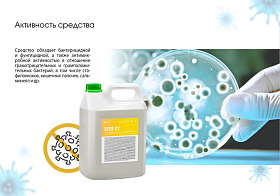
3 3

Для пищевой промышленности
55 товаров 2 073.94 i
Готовое к применению дезинфицирующее средство на основе изопропилового спирта DESO C9, 5 л В наличии 550055
3 485.42 i
Щелочное беспенное моющее средство Grass с содержанием активного хлора CIP 32, 19 л В наличии 550038
1 065.40 i
Дезинфицирующее средство с моющим эффектом на основе Grass ЧАС DESO C2, 5л В наличии 550066
4 109.88 i
Щелочное пенное моющее средство с содержанием активного хлора GIOS F1, 19л В наличии 550029
4 415.18 i
Средство до доения на основе молочной кислоты CLEAN LACT (канистра 20л) Нет в наличии 550086
5 049.28 i
Средство после доения на основе хлоргексидина PROTECT CL (канистра 20л) Нет в наличии 550089
3 992.46 i
Средство после доения на основе молочной кислоты PROTECT LACT (канистра 20л) Нет в наличии 550088
120 731.69 i
Щелочное беспенное моющее средство CIP 31, 1000 л (1330кг) оборотная тара, шт Нет в наличии 555006
5 916.81 i
Кислотное низкопенное моющее средство на основе ортофосфорной кислоты CIP 54, 19 л Нет в наличии 550056
8 934.98 i
Дезинфицирующее средство на основе 15% надуксусной кислоты DESO C4 (с электропроводностью) Нет в наличии 550080
14 912.98 i
Средство дезинфицирующее для объектов ветеринарного надзора DESO V , 20 л Нет в наличии 550084
528.00 i
Щелочное беспенное средство с содержанием активного хлора безопасное для мягких металлов CIP 35, 5л Нет в наличии 550060
5 006.54 i
Кислотное беспенное моющее средство на основе азотной кислоты CIP 50, 19,3 л Нет в наличии 550054
4 551.39 i
Нейтральное пенное моющее средство с содержанием ЧАС NEUTRAL F71, 19 л Нет в наличии 550044